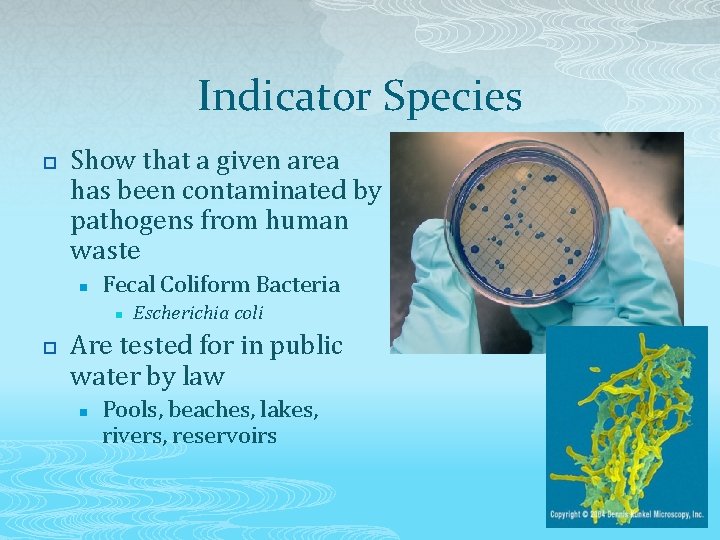
Indicator Species p Show that a given area has been contaminated by pathogens from

Water Pollution Water Pollution p p Is contamination

- Slides: 51
Water Pollution
Water Pollution p p Is contamination of surface or groundwater through human activity that negatively affects living things Can be animal waste, garbage, excess nutrients, chemicals, excess sediment
Sources of Pollution p Point Source n p Distinct locations that add pollutants to a body of water Nonpoint Source n Large areas and many contributors add pollutants to a body of water
Human Wastewater p p p Is produced from human activities such as cooking and bathing Most common global water pollutant Separating wastewater from drinking water has been a huge challenge n n Infrastructure Public health
Impacts of Wastewater p Releases organic nutrients n p Increases oxygen demand n p Causes eutrophication Reduces oxygen available to other aquatic organisms Releases disease-causing organisms n Public health problem
Oxygen-Demanding Waste p Is waste that carries organic material that can provide food for bacteria n n p p Sewage Plant matter This causes bacterial growth, which uses oxygen Extreme bacterial growth can cause dead zones
Biochemical Oxygen Demand (BOD) p p p Measures the oxygen use over a period of time at a given temperature Temperature has an effect because warmer water holds less oxygen Can show much organic matter has polluted a body of water
Nutrient Release from Waste p p Includes limiting nutrients like nitrogen and phosphorus Comes from bacteria during decomposition of organic matter
Eutrophication p p p Occurs when algae grow rapidly from increased nutrient levels When this occurs from human activity, it is called cultural eutrophication Can cause hypoxic zones when the bloom dies and decomposes
Disease-Causing Organisms in Waste p p p Are also called pathogens Include bacteria, viruses, and parasites Cause outbreaks when human wastewater mixes with drinking water n Cholera and hepatitis are the major wastewaterborne disease-causing agents worldwide
Indicator Species p Show that a given area has been contaminated by pathogens from human waste n Fecal Coliform Bacteria n p Escherichia coli Are tested for in public water by law n Pools, beaches, lakes, rivers, reservoirs
Wastewater Treatment p p Removes organic matter and pathogens from wastewater Has several methods n n n p Septic tanks Sewage treatment plants Manure lagoon Relies on beneficial bacteria breaking down organic matter and outcompeting pathogens
Septic Systems p Use a septic tank n n n Accepts waste Allows waste to settle into three layers First layer is floating scum Second layer is liquid septage Third layer is semisolid sludge
Septic Systems p Use a leach field n n n Uses pipes and gravity to move septage out of the tank Septage contains water and nutrients that seep out into the ground Soil filters and purifies water
Pros and Cons of Septic Systems Pros p Do not use energy to treat water p Can produce methane Cons p Can produce methane p Need a large area for leach field p Beneficial bacterial levels must be maintained or the system can fail p Sludge must be pumped out every 5 -10 years and taken for sewage treatment
Sewage Treatment Plants p p Remove human waste from water Can receive wastewater from households, businesses and storm drains Can recycle water for other uses Use two to three levels of treatment n n n Primary Secondary Tertiary
Primary Sewage Treatment p Involves settling and removal of solids from liquids in wastewater n Leftover sludge can be dried n n n Sent to a landfill Used for fertilizer Some areas have special permits to release liquid extracted from primary treatment directly into the ocean (effluent)
Secondary Sewage Treatment p Cleans the liquid remaining from primary treatment n n Bacteria are added to the liquid to digest the organic material Resulting liquid has 80 -90% of the organic material removed Liquid is held in tanks to let bacteria and any remaining solids settle out Effluent can be released into the environment
Tertiary Sewage Treatment p p Is required by some areas before effluent can be released into the environment Is done to ensure the death of all pathogens Can involve adding chemicals like chlorine to water Can involve exposing water to high levels of ultraviolet radiation
Sewage Overflows p p Occur during periods of high water flow that overwhelm treatment plants Can be legal Pollute surrounding waterways Can also occur from blockage And if that isn’t gross enough: Fatbergs in London’s Sewer System
Other Treatment Methods p Involve using natural systems to absorb nutrients from water n n n Constructed wetlands Marshes Swamps
Pros and Cons of Traditional Sewage Treatment Pros p Reduces illness from waterborne pathogens p Reduces pollution from increased organic matter p Can provide energy (methane) p Can provide nutrients for fertilizer p Can provide reusable water Cons p Expensive p Energy-intensive p People don’t want to reuse sewer water
Manure Lagoons p p p Are where animal wastes from CAFOs and farming are stored Are lined in rubber or plastic to prevent leaking Have bacteria added to digest organic waste n Undigested waste is dried and distributed as fertilizer Also: CAFOs from SPACE!
Toxic Chemicals p Mostly come from industrial processes n Metals n n n p Lead, arsenic, mercury, cadmium Acids Synthetic compounds Are used in agriculture and consumer products n Pesticides, cleaning chemicals, health and beauty products
Lead (Pb) p p p Can leach from pipes and contaminate water Causes nervous system and kidney damage Can be eliminated by removing lead pipes and filtering water
Arsenic (As) p p Exists naturally in the Earth’s crust and can leach into groundwater Mining tailings and industrial processes also produce arsenic Can cause cancer from chronic small doses over time or a large acute dose Has a safe limit of exposure at 10 μg/L (EPA), which may still be too much
Mercury (Hg) p p p Is added to the atmosphere by mining and burning fossil fuels Can also come from industrial processes and medical waste Gets into water through leaching or precipitation Converts to methylmercury Can bioaccumulate in fish Can cause nervous system damage in humans (Minamata disease)
Cadmium (Cd)* p p Is released from smelting and mine tailings Causes Itai-itai disease (“ouch-ouch” disease) Replaces calcium in bones, making them extremely brittle Can be absorbed by plant tissues, then bioaccumulate and biomagnify up a food chain
Acids p p Come from mining and industrial process Form from exposed rock that releases sulfur and hydrogen ions n p Form from burning fossil fuels that release sulfur and nitrogen compounds n p Make sulfuric acid in nearby water Make sulfuric and nitric acid in the atmosphere Accumulate in water and can dissolve even more toxic metals
Synthetic Chemicals p p p Come from industrial point sources or from agricultural or residential nonpoint sources Include pesticides, pharmaceuticals and cleaning agents Can cause many different health effects
Pesticides p p Can kill other organisms besides the intended target species Are made of a mixture of chemicals that may have yetundiscovered effects on organisms Get into water by direct spraying or from agricultural runoff Can bioaccumulate and biomagnify in a food chain
Pharmaceuticals and Hormones p Include prescription and OTC drugs, steroids, and reproductive hormones n Hormones and steroids operate in cells at small concentrations, so they have a larger impact n n Can lead to developmental defects Antibiotics may lead to increased bacterial resistance in nature
Industrial Waste p p Includes any chemical used in manufacturing and other industrial processes Was dumped into bodies of water as an easy disposal method n p No longer legal to dispose this way Include many types of chemicals n n n Perchlorates Polychlorinated biphenyls Polybrominated diphenyl ethers
Perchlorates (Cl. O 4) p p p Come from rocket fuel Leach into the ground from poorly disposed military and space waste Disrupt thyroid function n n Reduce hormone production Can cause birth defects
Polychlorinated Biphenyls (PCBs) p p p Were used to manufacture plastics and electronics until 1979 Are persistent, so they still exist in the environment today May not be in the water column, but have settled into bottom sediment Are carcinogenic Can bioaccumulate in fatty tissues and biomagnify in a food chain
Fossil Fuels p Contaminate water by leaked oil from drilling and transportation n p Hard to clean up Persistent Contains many toxic and carcinogenic compounds Can leak naturally n Called oil seeps
Cleaning Up Oil Spills p p Involves cleaning animals, plants, and their habitat Must be done by hand for wildlife n n Chemicals can destroy natural waterproofing Animals that survive may not be able to live in the wild
Cleaning Up Oil Spills p p Also involves preventing oil from spreading For underwater plumes: n n p Containment “curtains” stop spreading Vacuums or absorbent materials suck up oil For surface oil: n n Apply dispersants to break up oil in water Use high pressure water jets on shorelines
Other Types of Water Pollution p Are not chemicals themselves, but can contribute or elevate chemical pollutants n n Solid waste Sediment Thermal Noise
Solid Waste p p Includes garbage Is ugly Is dangerous to aquatic organisms Is a global problem as it travels far from its disposal site n Pacific Garbage Patch
Sediment p p p Is the addition of excess sand, silt, and/or clay to water Comes from poor farming techniques and deforestation Increases turbidity (cloudiness) of water n n p Reduces photosynthesis Clogs fish gills and buries invertebrates Can carry excess nutrients
Thermal Pollution p p Is excess heat added to water Comes from water used to cool power plants and factories Decreases the amount of oxygen in the water Causes thermal shock n Death of aquatic species due to extreme temperature change
Noise Pollution p p Is excess noise from shipping, military exercises, scientific exploration, and fossil fuel mining and prospecting Harms marine mammals n n Disrupts their communication May cause some biological damage
Keeping Drinking Water Safe p Involves federal legislation that mandates standards for water quality n n p Clean Water Act Safe Drinking Water Act Enforced by the EPA and state agencies n States may pass standards that exceed federal limits
Clean Water Act p p p Began as the Federal Water Pollution Act of 1948 Expanded in 1972 Sets out standards for maintaining and restoring the chemical, physical, and biological properties of surface water n p Does not protect groundwater Continues to be amended as needed n Addresses levels of specific pollutants
Safe Drinking Water Act p p Was passed in 1974 and has been amended as necessary Sets maximum contaminant levels (MCLs) for drinking water
Water Pollution in the Rest of the World p Is more of a problem in developing nations n n n p Lack of infrastructure Lack of legal structure Poor enforcement Is often due to rapid industrialization